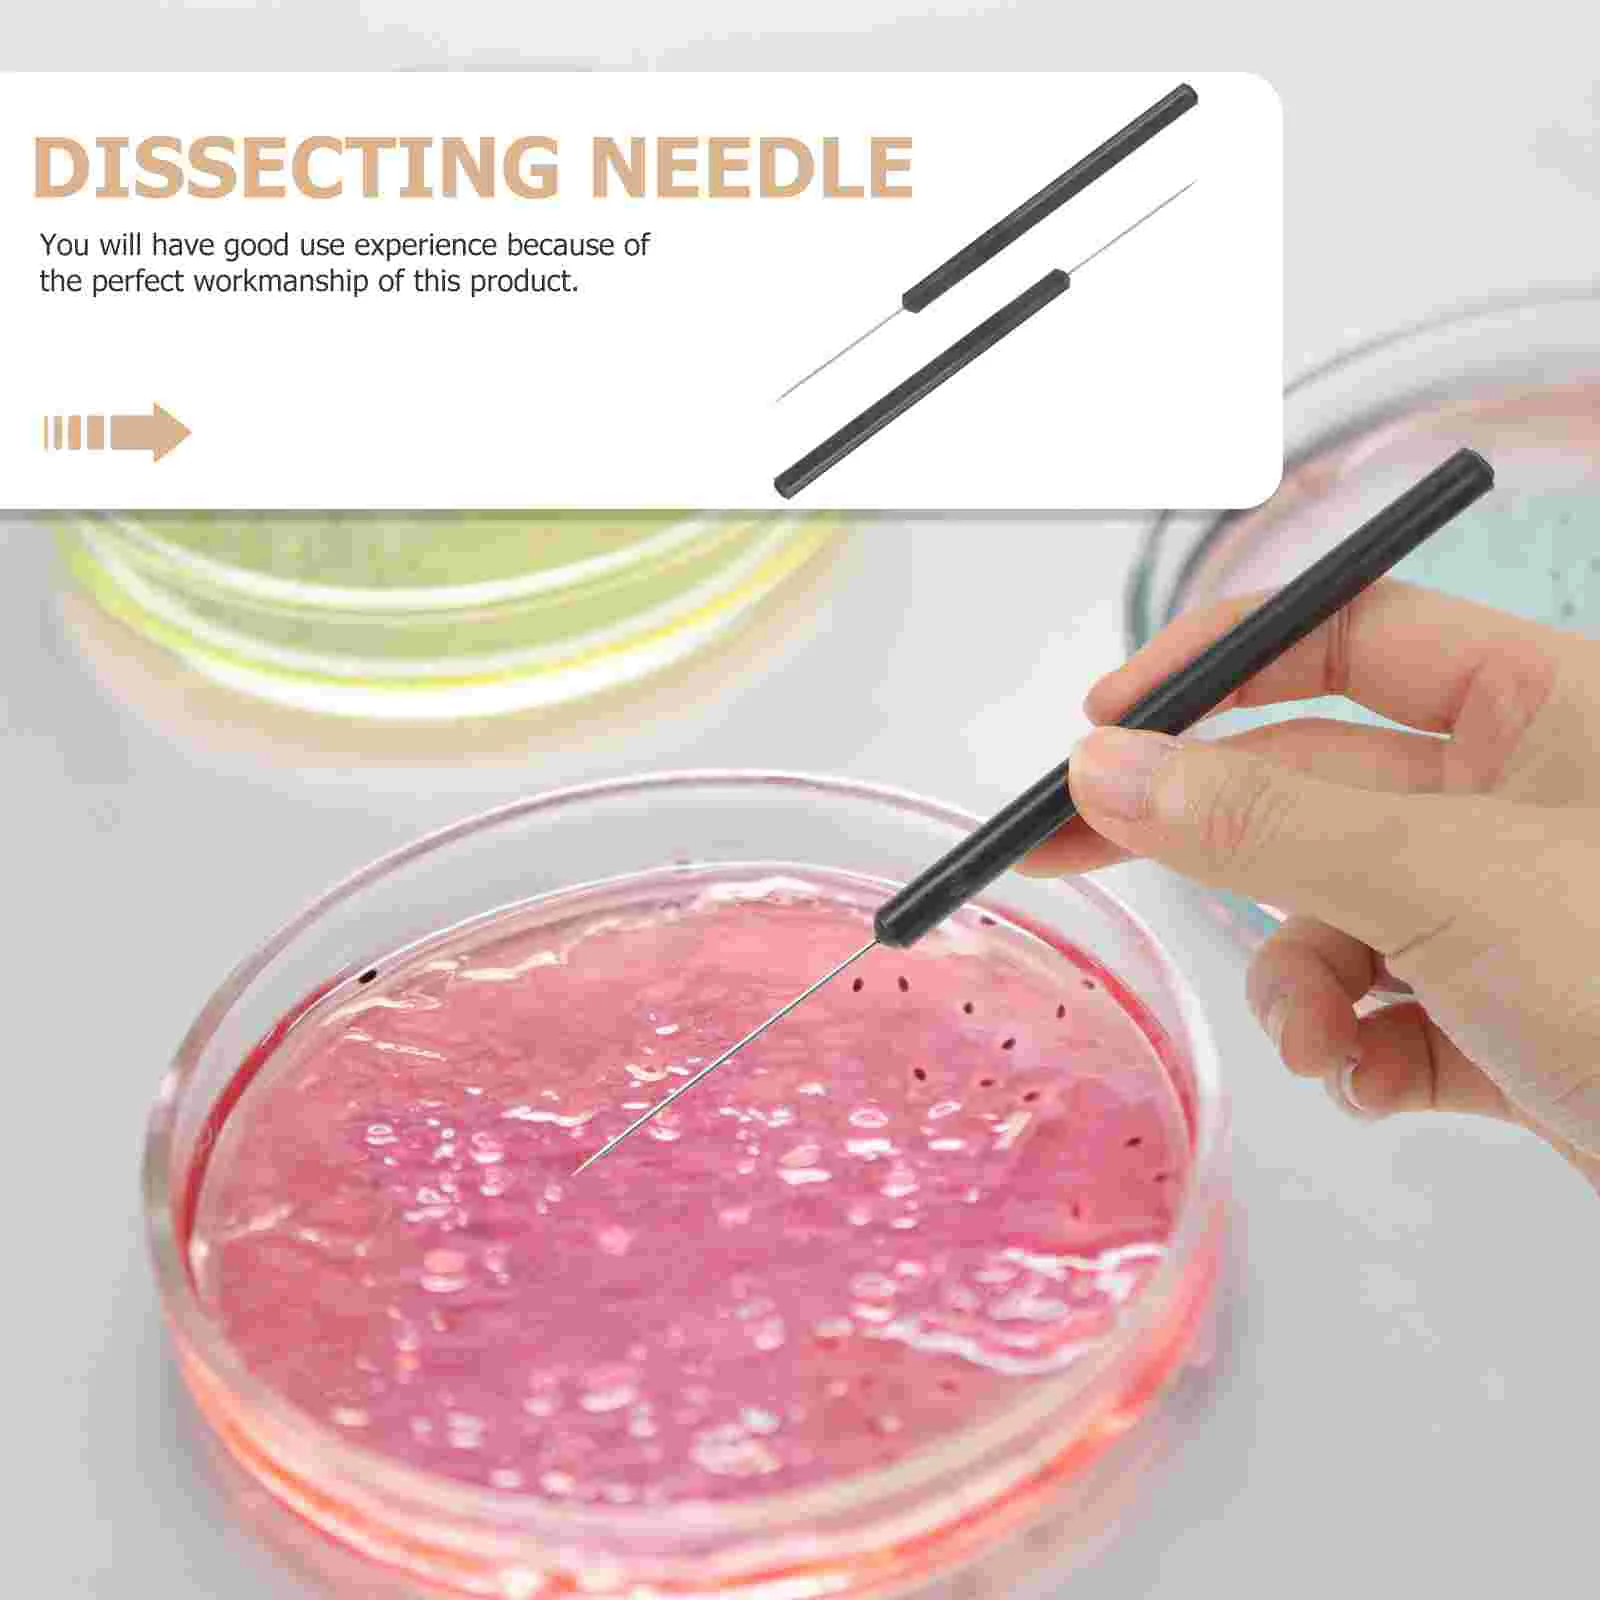
thumb

2 Pcs Insect Dissecting Needle Butterflies Dissection Tool Frog Entomology Plastic Anatomy
Price history chart & currency exchange rate
Customers also viewed

$1,742.52
Infrared Therapy Neuro Brain Helmet 810nm PDT Photobiomodulation Red Light For Parkinson Stroke Autism Head Massage Relaxation
aliexpress.com
$21.46
VCKA Aluminum magnesium Myopia Sunglasses Frame Fashion Men Magnetic Clip Polarized Custom Optics 3 in 1 Glasses -0.50 to -10
aliexpress.com
$29.93
R2LB BNC to HDMIcompatible Converters Adapter for Signal Conversion from AHDs CVIs TVIs CVBS to 1080P Video Converter Adapter
aliexpress.com
$19.05
Laptop Keyboard Cover Transparent Case Perspex Crafts Anti Cat Acrylic Stand Clear Protector
aliexpress.com
$2.64
Custom White Cardboard Color Box Printing Cosmetic Paper Box Kraft Paper Box Design Packaging Box Food Corrugated Box
aliexpress.com
$10.54
hot girls have problems too Tapestry Korean Room Decor Room Decoration Accessories Aesthetic Decoration Tapestry
aliexpress.ru
$7.69
Avatar Wisdom Baseball Cap Hat Man For The Sun Sunhat Uv Protection Solar Hat Hip Hop Baseball For Men Women's
aliexpress.ru
$211.98
550 Вт Коммерческая овощерезка Электрический измельчитель пищи Сталь измельчитель мяса Домашнего производства пельменей фарш машина
aliexpress.ru
$71.00
Длинные вечерние платья, платье для невесты, вечерние платья для выпускного вечера, Vestido De Festa
aliexpress.ru
$101.20
Материнская плата 6050A2848001-MB-A01 для ноутбука HP EliteBook X360 1030 G2 со стандартным процессором i7-7600U 8 ГБ/16 ГБ ОЗУ 920053-601 920054-601
aliexpress.ru
$330.66
WLtoys XKS 104072 Радиоуправляемый автомобиль 1/10 60 км/ч высокоскоростной внедорожник 4x4 автомобиль с дистанционным управлением 4WD бесщеточный двигатель гоночный автомобиль игрушка подарок для взрослых
aliexpress.ru
$9.44
WHNB 2022 маленькие белые женские осенние новые модные повседневные туфли на толстой подошве Спортивные Универсальные скейтборды для студенто...
aliexpress.ru
$18.37
45,2 мм цилиндр бензопилы поршневая игла комплект прокладок для 5800 58Cc цилиндр в сборе бензопила запасные части
aliexpress.ru
$37.99
Оранжевая нагревательная шаль для больших плеч, шеи, спины, фунтов, обогревательная подушка для облегчения боли
aliexpress.ru
$2.47
vixn6 autumn and winter women 2020 socks new socks liaoyuan cotton cotton socks dmfwq, Black
dhgate.com
$46.99
Answer 2-позиционная подставка-концентратор для док-станции Switch Organic EL, лежачая и стоячая [горизонтальная/вертикальная/функция USB-концентратора/наклон примерно на 20 градусов/TV boa
joom.ru
$120.58
Вытяжка наклонная Maan Dajmos Steel Matte/White Glass 60, Dajmos steel matte / white glass 60
goods.ru$1.69
Ins Korean Folding Rectangle Flower Box - Kotak Lipat - Hamper - Bunga Kue Kado Hadiah Macaroon
shopee.co.id
$5.32
Mens Cotton T Shirt Summer Tees Solid Color Crew Neck Short Sleeve Top Casual Fashion High Quality Cool Clothing
aliexpress.com
$843.84
Индивидуальный встроенный полный настенный книжный шкаф для гостиной, комбинация книжной полки, простой шкаф для хранения, многослойный книжный шкаф
aliexpress.ru
$96.46
EDECPBM Свадебные платья по индивидуальному заказу Гала-платья Женское вечернее платье Платье для особых случаев Платье из ткани с цветочным принтом Халат для выпускного вечера
aliexpress.ru
$5.90
2024 Ethnic style printed imitation silk scarf summer fashion outer shawl thin warm air conditioning blanket multifunctional
aliexpress.com